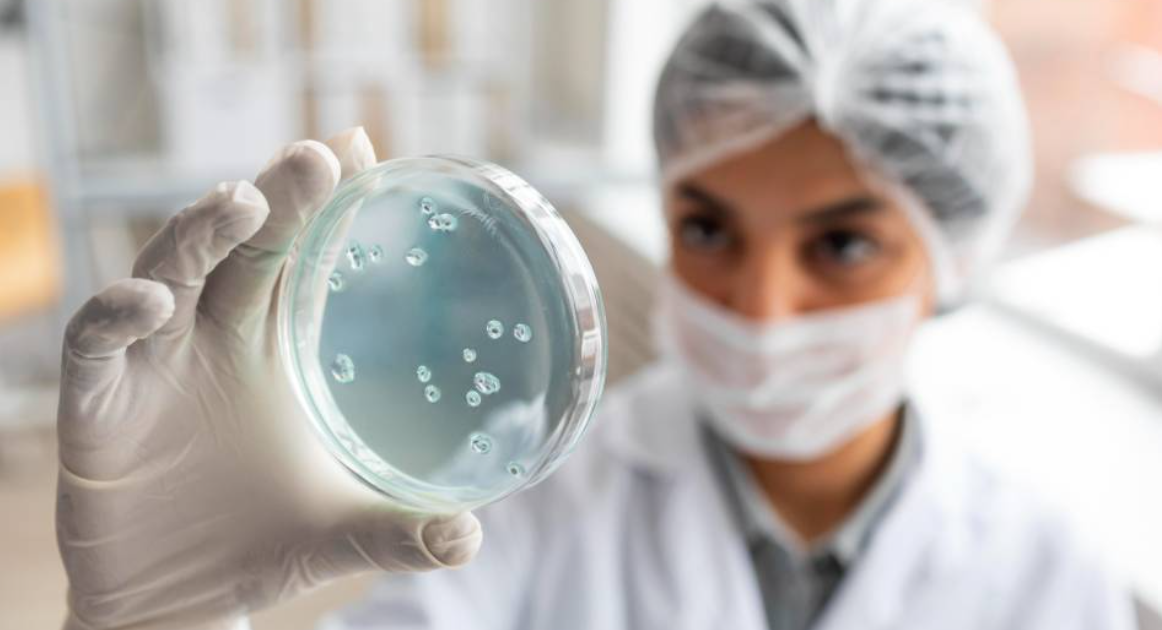

Por
Afya Itaperuna
Compartilhe
A Infectologia nunca foi tão falada quanto nos últimos anos. Em um mundo pós-pandemia, compreender e atuar nessa área vai muito além de tratar doenças: é proteger comunidades inteiras e antecipar crises de saúde.
Para quem sonha cursar Medicina, conhecer a Infectologia é abrir portas para uma carreira com impacto real, relevância crescente e oportunidades que unem ciência, cuidado humano e transformação social.
A Infectologia é a especialidade médica dedicada ao diagnóstico, tratamento e prevenção de doenças causadas por microrganismos como vírus, bactérias, fungos e parasitas.
No Brasil, o reconhecimento dessa área se intensificou após a pandemia, quando a necessidade de especialistas capazes de responder rapidamente a crises sanitárias ficou evidente.
Hoje, o papel do infectologista abrange não apenas o consultório e o hospital, mas também pesquisa científica, vigilância epidemiológica e educação em saúde.
Isso significa atuar para impedir surtos, reduzir impactos de doenças e orientar políticas públicas. No cenário atual, cada passo dessa atuação faz diferença para o bem-estar coletivo.
A pandemia de COVID-19 trouxe à tona fragilidades e fortalezas do sistema de saúde brasileiro. Ficou claro que a pesquisa científica, a testagem em massa, a vacinação e a comunicação clara com a população são ferramentas indispensáveis para conter crises sanitárias.
Instituições como a Fiocruz e o Instituto Butantan ganharam destaque mundial ao desenvolver vacinas, produzir diagnósticos e combater a desinformação.
Para o futuro, o desafio é manter essa capacidade de resposta rápida, mas com foco também em doenças já conhecidas, como dengue e tuberculose. A Infectologia, nesse cenário, assume o papel de guardiã da saúde coletiva, unindo conhecimento técnico e ação social.
Se antes da pandemia a Infectologia já tinha importância, o cenário atual mostrou que ela é estratégica para manter a saúde coletiva e evitar novos colapsos.
O trabalho do infectologista é multifacetado, abrangendo desde a assistência clínica até o desenvolvimento de políticas públicas e pesquisas científicas.
Hoje, esse especialista atua em várias frentes:
https://giphy.com/gifs/mcgillu-mcgill-university-library-1wPAqSWsoZdz3qY6eA
Um ponto essencial é que o infectologista não atua isoladamente. Ele faz parte de equipes multidisciplinares com médicos de outras áreas, enfermeiros, farmacêuticos, biólogos e gestores de saúde.
Essa integração garante que as ações sejam mais efetivas e que as decisões sejam baseadas em evidências.
Em fóruns e eventos científicos, como os promovidos pelo Conselho Federal de Medicina (CFM), esses profissionais têm protagonizado debates sobre o controle de doenças emergentes e a necessidade de ampliar investimentos na área.
Essa presença ativa reforça que a Infectologia é mais do que uma especialidade: é um pilar de sustentação da saúde pública brasileira.
Para jovens como a Julia, que sonham em seguir Medicina, a Infectologia pode ser uma escolha inspiradora e estratégica.
Essa especialidade oferece a chance de atuar em problemas de grande impacto social, onde cada diagnóstico correto e cada medida preventiva pode mudar a vida de centenas de pessoas.
Entre os fatores que tornam a Infectologia tão atrativa:
Mesmo após o fim do pico da pandemia, doenças infecciosas continuam sendo uma das maiores ameaças à saúde global.
O profissional dessa área está sempre em demanda, tanto no setor público quanto privado.
https://giphy.com/gifs/uregina-science-lab-laboratory-gjAd5llUlKZjom2iuL
Novas doenças surgem, velhas doenças reaparecem, a atualização profissional é constante. Participação em congressos, pesquisas e missões de campo que exigem proatividade e curiosidade científica.
A Infectologia também se destaca como uma especialidade de forte interdisciplinaridade. O médico precisa dialogar com imunologistas, epidemiologistas, clínicos gerais e profissionais de saúde coletiva, o que amplia sua visão e rede de contatos.
Para quem deseja uma carreira que seja ao mesmo tempo científica, humana e estratégica, poucas áreas oferecem tantas oportunidades de crescimento e realização pessoal.
A Infectologia mostrou ao mundo que é mais do que uma especialidade: é uma linha de defesa essencial contra ameaças à saúde coletiva.
Com nossa experiência recente, ficou claro que precisamos de profissionais preparados, comprometidos e atualizados para enfrentar tanto doenças conhecidas quanto novos desafios.
Para quem sonha em cursar Medicina, esse campo é um convite para unir ciência, propósito e impacto social. E se você quer dar o primeiro passo nessa jornada, o curso de Medicina da Afya Itaperuna oferece formação completa, estrutura moderna e professores experientes para preparar você para qualquer desafio.
Descubra como ingressar e transformar seu sonho em realidade: clique aqui e conheça o curso de Medicina da Afya Itaperuna!